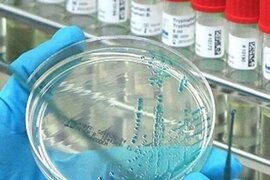
.

Sağlamlıq xəbərləri
Erkən qırışlara səbəb olan beş vərdiş açıqlandı
Üzdəki qırışların görünüşünü gecikdirmək üçün dəriyə düzgün qulluq etmək vacibdir. Ancaq bu prosesi əhəmiyyətli dərəcədə sürətləndirə biləcək gündəlik hərəkətlərdən qaçınmaq da eyni dərəcədə vacibdir. Qaynarinfo xəbər verir ki, bu barədə kosmetoloq Yana Katina -ya danışıb. Mütəxəssis vaxtından əvvə
22 avqust
Ən faydalı pendir hansıdır?
Sağlam qidalanmanın vacib hissəsi olan pendir, yüksək protein və kalsium tərkiblidir. Səhər yeməyi və naharın vazkeçilməzidir. Ancaq son araşdırmalar bütün pendirlərin eyni qida dəyərinə və faydalara malik olmadığını ortaya qoyub. xəbər verir ki, qidalanma mütəxəssisləri xüsusilə müəyyən pendirləri
21 avqust
Alimlər xəbərdarlıq edir: Asqırmanı saxlamaq damarları partlada bilər
Asqırmağı saxlama vərdişi insultla nəticələnə bilər. Ölkə.az "NSC Total"a istinadla xəbər verir ki, bu sözləri Miçiqan Universitetinin nevroloqu Baybinq Çen deyib. Onun sözlərinə görə, asqırma zamanı orqanizmdə avtomobil təkərlərindən daha yüksək təzyiq yaranır:. "Əgər bu prosesi saxlamağ
21 avqust
Mütəxəssislər hər gün artıq yeməyin qarşısını almaq üçün sadə üsullar təqdim edirlər
Düzgün qidalanma vərdişləri və bir neçə sadə texnika artıq yeməyin qarşısını almağa, sağlam çəkini qorumağa və xroniki xəstəliklərin yaranma riskini azaltmağa kömək edə bilər. -a istinadən xəbər verir ki, "Live Strong" saytının yazdığına görə, bu üsulları gündəlik həyatınıza daxil etmək faydal
20 avqust
Masajın Əsas növləri və Faydaları hansılardı?
Masaj həm bədən, həm də ruh üçün əvəzolunmaz rahatlama vasitəsidir. Amma hər masaj növü fərqli məqsəd daşıyır və müxtəlif insan qrupları üçün nəzərdə tutulub. Doğru masaj növünü seçmək bədənin ehtiyaclarını ödəmək və sağlamlığı qorumaq baxımından çox vacibdir. Klassik Masaj. Klassik masaj ən çox yayıla
20 avqust
Ventilyator ürək tutmasına səbəb olur - XƏBƏRDARLIQ
İsti havada ventilyatordan istifadə ürək tutmasına səbəb ola bilər. Ölkə.Az xəbər verir ki, bu barədə Avstraliyanın Sidney Universitetində araşdırma aparılıb. Araşdırma çərçivəsində 20 nəfər könüllü iştirakçı 39 dərəcə Selsi temperatur və 49% rütubətdə qurulmuş iqlim kamerasında 3 saatlıq dörd fərql
19 avqust
Tənhalıq şəxsiyyəti, yuxunu və hətta beyin funksiyasını dəyişir
Beynəlxalq alimlər qrupu tənhalığın təkcə əhval-ruhiyyəyə deyil, həm də şəxsiyyətə, beyin funksiyasına, immunitet sisteminə və hətta yuxulara da təsir etdiyini müəyyən edib. Qaynarinfo xəbər verir ki, tədqiqat "Nature Human Behavior" (NHB) jurnalında dərc olunub. Yalnızlıq getdikcə daha ço
19 avqust
Latte, yoxsa espresso? - Ən zərərli qəhvə
Şirin əlavələrlə içilən qəhvə sağlamlığa daha çox zərər vurur. Ölkə.az " "ya istinadla xəbər verir ki, bu barədə diyetoloq Tatyana Selezneva danışıb. Onun sözlərinə görə, latte, amerikano, espresso və digər qəhvə içkiləri zərərli deyil, lakin onların qəbul olunma vaxtı və miqdarı orqanizm
19 avqust
İnsanlar yuxuda niyə danışır?
Yuxuda danışmaq, istər bir sözlə, istərsə də uzun cümlələrlə olsun, göründüyündən daha geniş yayılmış bir haldır. Ancaq bu qədər tez-tez baş verməsinə baxmayaraq, alimlər hələ də onun səbəbini tam aydınlaşdıra bilməyiblər. xəbər verir ki, çox vaxt yuxuda danışmağın konkret səbəbi olmur. Əgər kimsə siz
19 avqust
Sağlamlığın və gözəlliyin daha bir sirri açıldı
Sınanmış və müxtəlif xəstəliklərin müalicəsində istifadə edilən təsirli üsullardan bəziləri həm də sizi gözəlləşdirir. xəbər verir ki, sağlıq üçün səhər-səhər acqarına bir piyalə bal şərbəti içmək məsləhətdir. Tərlədikdə ayaqdan pis qoxu gələrsə, yarpız, yovşan, sarıçiçək bitkiləri atılmış qaynanmı
19 avqust
Uşaqlar sürətlə qocalır, ömrü qısalır - Progeriya xəstəliyi nədir?
Progeriya uşaqlarda sürətlə qocalmağa səbəb olan son dərəcə nadir genetik xəstəlikdir. Hal-hazırda xəstəliyin qəti müalicəsi yoxdur və bəzi dərmanlar ömrü uzatsa da, orta ömür 13-15 il ilə məhdudlaşır. medicina-ya istinadən xəbər verir ki, tibbdə erkən yaşlanma kimi tanınan progeriya çox nadir rast gəlinə
18 avqust
Dişlərinizi bu gündəlik vərdişlər məhv edir
Diş çöpündən istifadə diş problemlərinə səbəb ola bilir. Ölkə.az " "ya istinadla xəbər verir ki, bu barədə stomatoloq Uqo Roberto Levgoy danışıb. Onun sözlərinə görə, bir çox gündəlik vərdişlər zərərsiz görünsə də, əslində dişlərə ciddi ziyan vurur:. "Qələm qapaqlarını gəmirmək və ya buz
18 avqust
100 ildən sonra insan ömrü nə qədər olacaq?
100 il əvvəl insanların ömür gözləntisi 50 ilə belə çatmırdı, bu gün isə qocalıq həddi 80 yaş hesab olunur. Bəs 100 ildən sonra vəziyyət necə olacaq?. Qaynarinfo xəbər verir ki, indiyə qədər rəsmi olaraq qeydə alınmış ən uzunömürlü insan Janna Kalman olub. O, 122 ilə qədər yaşayıb və 1997-ci ildə dünyasın
18 avqust
Qaraciyər xərçənginin əsas səbəbləri
Böyük bir analiz nəticəsində qaraciyər xərçənginin əksəriyyətinin qarşısının alınması viral hepatitlərin, alkoqoldan sui-istifadənin və metabolik ilə əlaqəli qaraciyər yağlanmasının (MASLD) yayılmasının qarşısını almaq olar. -ın xarici mediaya istinadən məlumatına görə, qaraciyər xərçəngi bu gün xərçəngi
17 avqust
Duzlu yeməklər beyinə zərər verir
Duzlu yeməklər beyinə ciddi zərər verə bilər. xəbər verir ki, terapevt və dietoloq Elvira Fasenko bildirib ki, gündəlik duzun çox qəbulu beyində qan dövranını pozur, təzyiqi yüksəldir və damar mənşəli demensiya riskini artırır. O qeyd edib ki, beyin çox enerji tələb edən orqandır və neyronlar üçün davaml
17 avqust
Beyni məhv edən xəstəlik tapıldı - Qısa zamanda öldürür
ABŞ-nin Missuri ştatında bir nəfər Ozarks gölündə üzdükdən sonra nadir və təhlükəli xəstəliyə yoluxub. xəbər verir ki, xəstəliyə "Naegleria fowleri" adlı kiçik amöb səbəb olub. Bu amöb nadir hallarda insana yoluxur, amma yoluxduqda beyini zədələyir və çox sürətli inkişaf edərək ölümə gətir
17 avqust
Ayaqdakı şişkinliyi yox edən 6 üsul - Həkim açıqladı
Ayaqlarda şişkinlik həm xəstəliklərin simptomu, həm də sağlam insanda fizioloji vəziyyət ola bilər. bildirir ki, həkim-terapevt Nadejda Çernışova -ya verdiyi açıqlamada bildirib ki, Əgər şişkinlik davamlı və ya tez-tez yaranırsa, bu ürək çatışmazlığı, varikoz xəstəliyi, böyrək problemləri (üzdə şişkinlikl
17 avqust
Qan təzyiqi olanlar bu balıqlardan uzaq dursunlar
Hipertoniyada bəzi balıq növlərinin seçilməsi zərərli ola bilər. Xüsusilə iki məşhur növ yüksək miqdarda natrium ehtiva edir ki, bu da arterial təzyiqin artmasına səbəb olur. Bu barədə -a istinadən məlumat verir. Balıq tez-tez omeqa-3 yağ turşuları və sağlamlığı dəstəkləmək qabiliyyəti ilə qiymətləndirils
17 avqust
Çox tərləyən qadınların nəzərinə - Ginekoloqdan xəbərdarlıq
Qadın sağlamlığı ilə bağlı kritik əlamətlər açıqlanıb. xəbər verir ki, rusiyalı ginekoloq Olqa Kaplina qadın sağlamlığında yaranmış problemləri xəbər verən bir sıra əlamətləri açıqlayıb. Həkim bu məlumatları paylaşaraq qadınların diqqətli olmasını tövsiyə edib. Kaplinanın sözlərinə görə yorğunluq v
16 avqust
Bağırsaq bakteriyası yuxusuzluğa səbəb ola bilər
Nankin Tibb Universitetinin alimləri bağırsaqda Odoribacter bakteriyalarının sayının artmasının yuxusuzluq riskini artırdığını müəyyən ediblər. xəbər verir ki, bu araşdırmanın nəticələri nüfuzlu "General Psychiatry" (GenPsy) jurnalında dərc olunub. Tədqiqatda mendelvari təsadüfiləşdirmə (MPR
16 avqust
Uşaq beyin xərçənginin təkrarlanmasının səbəbi aşkarlandı
Sanford Burnham Prebys Tədqiqat Mərkəzinin alimləri müəyyən ediblər ki, uşaqlarda aqressiv beyin xərçəngi növlərindən biri olan neyroblastomanın yenidən yaranmasının səbəblərindən biri xromosomlardan kənar yerləşən dairəvi DNT elementləri - halqavari xromosoməvəzi DNT (vkDNK) strukturları ola bilər
16 avqust
Çox qəhvə ziyandı
Dünyada milyonlarla insan səhər oyanan kimi günə kofe içməklə başlayır. Lakin mütəxəssislərin fikrincə, qəhvə içmək üçün ən sağlam vaxt 09.30-11.30 olmalıdır. Çünki kortizol hormonunun azaldığı saatlarda qəhvə içmək enerjimizi artırır. Axşam.az xəbər verir ki, qəhvə geniş şəkildə istehlak edilən bi
16 avqust
Gənclərin 3 yanlış vərdişi bu xəstəliyə səbəb olur - DİQQƏT!
Adətən 50 yaşdan sonra müşahidə olunan beyin qanaması (insult) son illərdə gənclərdə daha çox müşahidə olunur. Ölkə.Az xəbər verir ki, bunu türkiyəli beyin və neyrocərrahiyyə üzrə dosent Dr. Ali İhsan Ökten deyib. O bildirib ki, bu daha çox arteriovenoz malformasiyalar və anevrizmalardan qaynaqlanır:
15 avqust
"Beyin yeyən" infeksiya aşkarlandı
Missuri ştatının Səhiyyə və Yüksək Xidmətlər Departamenti yetkin bir insanın nadir ölümcül beyin infeksiyasına səbəb ola bilən "Naegleria fowleri" infeksiyasına yoluxduğunu açıqlayıb. Teleqraf-a istinadən xəbər verir ki, infeksiya amebik meningoensefalit və ya PAM adlanır. Xəstəlik "beyi
15 avqust
Bu gün eynəkləri TƏHLÜKƏLİDİR
Xarici görünüşü estetik ola da, bəzi gün eynəkləri sağlamlıq üçün olduqca böyük təhlükə yaradır. Bunlara əsasən qiyməti ucuz və səyyat satış arabalarında alıcılara təqdim edilən eynəklər daxildir. Bu cür eynəklər sağlamlıq baxımından ciddi risklər yaradır. xarici KİV-ə istinadən xəbər verir ki, onu
14 avqust
Təzə yumurtanın ömrü nə qədərdir?
"Təzə yumurtaların maksimum saxlanma müddəti bir aydır, lakin bir sıra şərtlərə əməl olunmalıdır". Ölkə.az " "ya istinadla xəbər verir ki, bu barədə diyetoloq Vanessa Cilio danışıb. "Soyuducuda yumurtaları düzgün saxladıqda, qabığını zədələmədən və kəskin qoxulu məhsullarla yanaş
14 avqust
Bu qidalar depressiyadan çıxarır
Mütəxəssislərin fikrincə, düzgün qidalanma psixi sağlamlıq üçün böyük rol oynayır. xəbər verir ki, bəzi qidalar beyində "xoşbəxtlik hormonları"nın istehsalını artıraraq depressiya əlamətlərini yüngülləşdirə bilər. 1. Yağlı balıqlar - Somon, skumbriya, sardina kimi omeqa-3 yağ turşuları zəngi
14 avqust
Saçdan hazırlanan diş pastası kariesi surətlə sağaldırmış
Britaniya alimləri müəyyən ediblər ki, saçdan hazırlanan diş pastası zədələnmiş dişləri bərpa edə və çürüklərin qarşısını ala bilər. Ölkə.az xəbər verir ki, bu barədə Daily Mail yazıb. Qeyd edilib ki, London Kral Kollecinin tədqiqatçıları insan saçından və ya yundan əldə edilən keratinin zədələnmiş di
14 avqust
Hər kəsin mətbəxində var: İnsanı ölümə aparır
Çaydanda yığılıb qalan ərp insan həyatı üçün çox təhlükəlidir. -a istinadən xəbər verir ki, bunu rusiyalı uroloq-androloq Vladimir Stepanov bildirib. O, ərp bağlayan çaydandan içilən suyun insanın sağlamlığına təsirindən danışıb:. "Çaydanda ərpin yığılması çox pisdir. O, əvvəlcə su ilə mədəyə daxi
14 avqust
Yayda nə qədər su içmək lazımdır - Mütləq bunları bilməlisiz!
Yay mövsümündə mayeni ya həddindən artıq, ya da kifayət qədər qəbul etməmək çox vaxt ödemlərin yaranmasına səbəb olur. xəbər verir ki, bu barədə " "ya dermatoloq və kosmetoloq Qalina Amosova məlumat verib. "İlk növbədə yüksək temperatur qan damarlarının genişlənməsinə səbəb olur ki, nəticəd
14 avqust
Bu şəxslər yaşa görə 220 manat müavinəti daha tez ala bilər
Azərbaycanda daha bir bayram günü iş olmayacaq
Mülayim payızdan sonra qış çox sərt keçir - Ekoloqdan XƏBƏRDARLIQ
İran məhsullarının satışı ölkədə niyə qadağan olunmur? - SOSİOLOQ AÇIQLADI
"Ayın 4-ü evə buraxıldı, 5-i öldü" - Həkimləri ittiham edirlər
Qəzaya uğrayan AZAL təyyarəsinin içindən heç yerdə görmədiyiniz KADRLAR - Hökümə Əliyeva son dəfə sərnişinləri salamlayır
Vətəndaş ilə qızıl satıcısı arasında alış-veriş zamanı baş verən maraqlı anlar gündəm oldu - VİDEO
Sabah leysan xarakterli yağış yağacaq - HAVA PROQNOZU
Dəm qazının qurbanı olan 18 yaşlı Leylinin - Fotoları
Çox öskürmək ziyandır
"Sədərək"də fəhlə bankomatdan sahibkarın pullarını oğurladı
Röya Ayxan atası Yaqub Nəcəfovla bağlı danışdı
İşçiləri aparan mikroavtobus aşdı: 12 nəfər yaralandı (YENİLƏNİB)
"Belə əlamətlərin məktəb psixoloqu və pedaqoji heyət tərəfindən vaxtında qeydə alınması və müdaxilə edilməsi qanunvericiliyin də tələbidir"
Ziya Məmmədovun səs-küylü tələbə yoldaşının oğlu - Yarım milyon mənimsəyib
